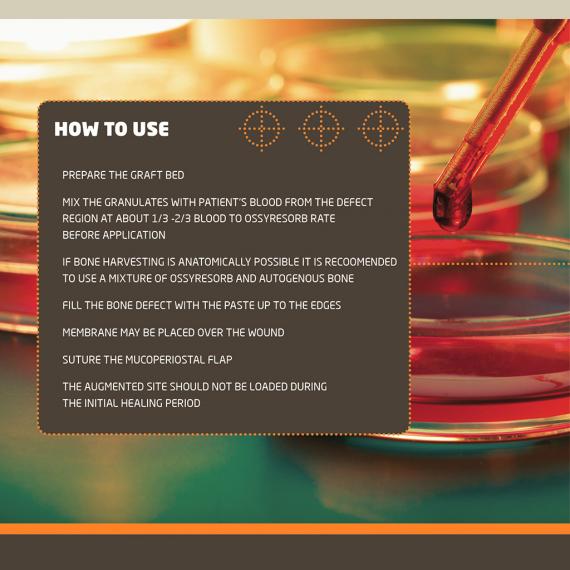

BONE AUGMENTING


BONE AUGMENTING MATERIALS
OSSYRESORB is a totally absorbable augmentation material for the treatment of bone loss. It is resorbed simultaneously while autologous bone is forming. B-tricalcium phosphate is fully absorbable. The porous material has very similar biological features to natural bone. It shows very good post-surgical stability.